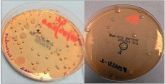
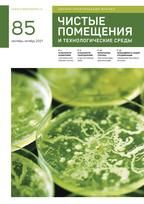

ЧИСТЫЙ БАРЬЕР
Важность качества поверхностей: характеристики фармацевтического оборудования и адгезия микроорганизмовВажным фактором при выборе оборудования для чистых помещений является обработка и шероховатость поверхности, особенно когда речь идет о нержавеющей стали, учитывая частоту использования этого материала, как и анодированного алюминия, при изготовлении фармацевтического технологического оборудования.